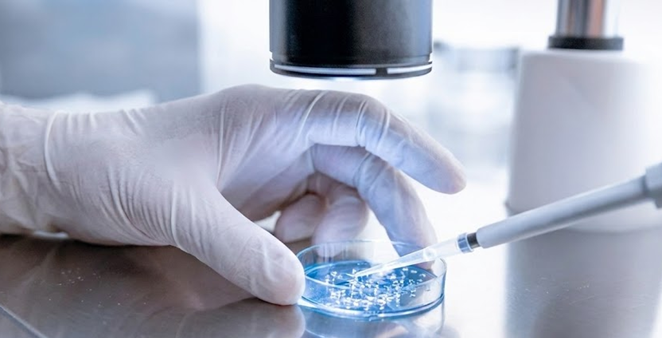

老化による課題を
バイオテクノロジーで解決する

2026/07/01
株式会社リジェネソーム(本社:東京都、以下「リジェネソーム」)は、国立大学法人東京農工大学の応用化学専攻の内田紀之特任講師との共同研究の成果として、レチノイド(ビタミンAとその誘導体の総称 、レチノー...

2026/03/26
リジェネソーム株式会社(本社:東京都港区、代表取締役:佐久間善太郎、以下「リジェネソーム」)は、株式会社FastNeura(本社:東京都文京区、代表取締役CEO:水口成寛、以下「FastNeura」)...
2026/03/24
スペースシードホールディングス株式会社(本社:東京都港区、代表取締役:鈴木健吾)の子会社であり、「老化による課題をバイオテクノロジーで解決する」ことをミッションとするリジェネソーム株式会社(本社:東京...

当社の親会社であるスペースシードホールディングス株式会社は、2024年4月より宇宙食の新たな可能性を拓くスペースフードスフィアに参画し※1、研究開発を加速させてきました。さらに、同年5月からは、人類の健康寿命延伸を目指す世界的なコンテスト「XPRIZE Healthspan」に参加し※2、エクソソーム解析技術を用いた革新的なヘルスケア製品開発やメディカル分野での技術開発に注力してきました。
これらの取り組みを通じて培われた、宇宙と生命科学に関する深い知見と広範な研究ネットワークを基盤に、当社は新たな挑戦に乗り出します。人類の健康寿命を大幅に延ばす革新的な技術開発を目的とした新会社を設立することで、老化をコントロールする技術の開発を通じた社会に貢献を果たす研究開発事業に取り組みます。
※1 スペースフードスフィアに参画のプレスリリースhttps://prtimes.jp/main/html/rd/p/000000001.000140650.html
2040年に人類が月面に生活圏を拡大するために必要となる地上にも
応用可能な老化防止技術を提供すること
2030年に健康寿命を延伸する老化防止の技術を実証すること
・エクソソームの科学的知見の蓄積
・宇宙科学の実践に関するネットワークの構築
・地球及び宇宙における抗老化等の健康面での課題解決のための研究開発
| 会社名 | リジェネソーム株式会社 |
|---|---|
| 設立日 | 2024年 7月 12日 |
| 代表取締役 |
鈴木 健吾 博士(農学、医学) 佐久間 善太郎 経営学修士 米国公認会計士 |
| 所在地 |
〒108-0074 東京都港区高輪2-21-1 THE LINKPILLAR 1 NORTH 6F LiSH 6Fに本社兼ラボスペースを構えています。7FにはLiSHのイベントスペースがございます。 |
| 事業内容 |
|
2005年に東京大学大学院農学生命科学研究科修士課程在学中にユーグレナ社を共同で設立。2016年博士(農学)学位取得、2019年博士(医学)学位取得。リジェネソームの親会社であるスペースシードホールディングス株式会社の代表取締役のほか、理化学研究所チームリーダー、東北大学特任教授(客員)を兼務し、当社の研究開発を担当する。
2004年東京大学経済学部卒、NTTドコモで営業・財務、金融庁で国際調整係長を務める。2018年から株式会社Unitedlyの副社長、2021年に株式会社Eパートナーに入社し取締役経営企画部長を務める。2024年よりスペースシードホールディングス株式会社の取締役に就任するとともに当社の代表取締役社長として事業推進を担当する。米国公認会計士、ニューヨーク大学MBA。

